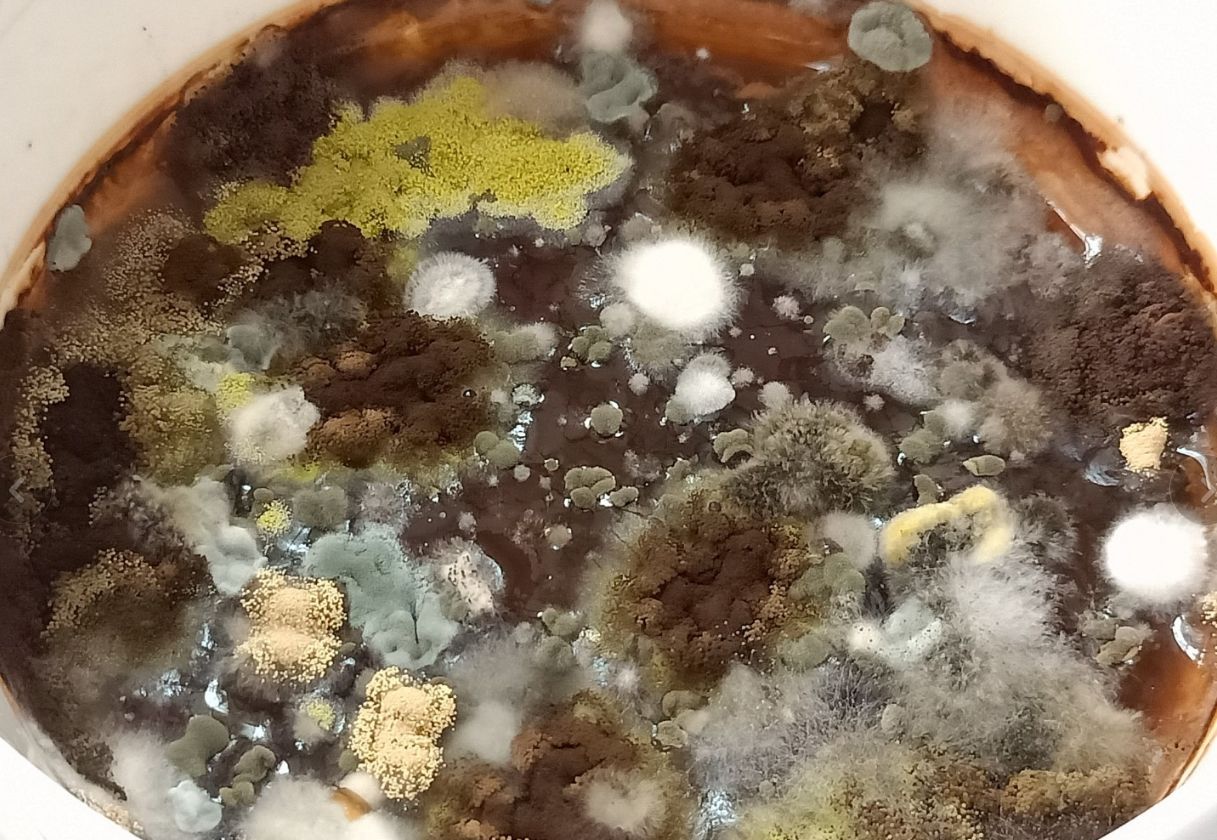
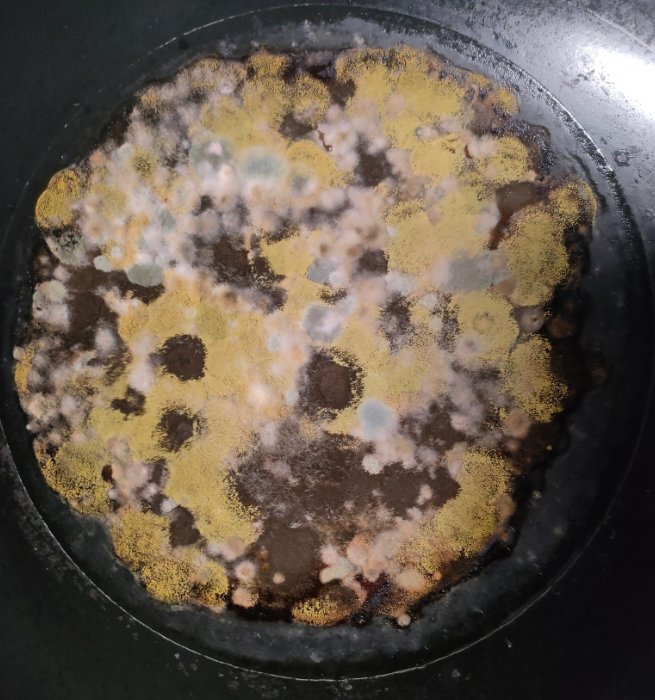

这个世界上的的生物多样性这么丰富的吗?在网上看到了一个关于霉菌的内容,网友们纷纷晒出了自己生活中偶遇的霉菌照片,
其中,有因遗忘而“发酵”两天的中药渣,其上竟悄然生长出形态各异的霉菌

中药渣两天忘记倒 杂色曲霉 剧毒
杂色曲霉可引起皮肤曲霉病,也可产生杂色曲霉毒素而致肝癌、胃癌等。
网友:丢了一周的中药,觉得很神奇就拍了

周五的饭,周一才发现
有人分享了自己彩色米饭上的霉菌

忘记刷的锅
褐色的构巢曲霉,不仅因独特的颜色引人瞩目,更因其潜在的危险性让人不敢小觑。
还有颜料盘上的菌

褐色 构巢曲霉

卖水果的时候发现的

这是什么菌啊,莫非是传说中的太上老菌!!!
快让我看看你们还见过什么菌!!
图侵删
更多游戏资讯请关注:电玩帮游戏资讯专区
电玩帮图文攻略 www.vgover.com


















